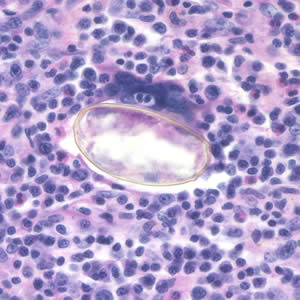
Case195_D.jpg Case195

Case #195 – January, 2007
A patient complaining of intermittent symptoms including coughing up blood, fever, and other vague “flu-like” symptoms saw a physician. The patient reported working at a sushi restaurant and eating a raw crab on a dare (Figure A shows a crab similar to the one that the patient ate). Blood tests were ordered and results included peripheral eosinophilia of 10% and a history of bilateral pneumothorax (free air or gas in the pleural cavity). A biopsy yielded a cyst containing a structure 5 mm in length and 2 mm in width. Figure B (40×) and Figure C (100×) show a hematoxylin and eosin (H & E) stained section of the specimen. Figure D (400×) shows an object which measured 80-90 µm by 40-45 µm. Similar objects were found in low numbers in sections of lung tissue. What is your diagnosis? Based on what criteria?

Figure A

Figure B

Figure C
Figure D
Images presented in the DPDx case studies are from specimens submitted for diagnosis or archiving. On rare occasions, clinical histories given may be partly fictitious.
DPDx is an educational resource designed for health professionals and laboratory scientists. For an overview including prevention, control, and treatment visit www.cy118119.com/parasites/.


